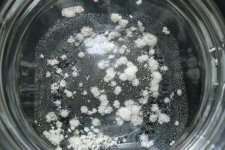
CIMG0626.JPG

resonanting_sloth
Rising Star
I'm doing STB from mimosa bark, pulling with naphtha, evaporating ~40%, and freeze precipitating dmt crystals. For whatever reason, my later pulls have crashed out nice amounts of dmt, but the crystals are tiny, granular, and not sticking to the jar at all. This makes collection a bit trickier.
I'm more used to filtering things to gain a clean filtrate as opposed to keeping the residue. In this case, I don't want the naphtha to warm up and re-dissolve the dmt. I do not have proper filter paper right now- only coffee filters.
1) I could pre-treat the filter with naphtha from the jar.
2) I don't want to do the filtration process in the freezer, as it is used for food.
3) I want to minimize loss both to the filtrate and to absorption into the filter.
I suppose losses would be minimal, but I wonder if there are any tricks I can use for simple gravity filtration. I'd rather not end up with a dmt-impregnated piece of paper, even though it would be a simple matter to put that small amount of dmt back into solution. Long ago, I had a couple filtration processes like this go sideways on me in the past, so I'm a bit scared of filtration. (trying to remember what those projects were...sadly, I can't)
Thanks,
Slotherson
I'm more used to filtering things to gain a clean filtrate as opposed to keeping the residue. In this case, I don't want the naphtha to warm up and re-dissolve the dmt. I do not have proper filter paper right now- only coffee filters.
1) I could pre-treat the filter with naphtha from the jar.
2) I don't want to do the filtration process in the freezer, as it is used for food.
3) I want to minimize loss both to the filtrate and to absorption into the filter.
I suppose losses would be minimal, but I wonder if there are any tricks I can use for simple gravity filtration. I'd rather not end up with a dmt-impregnated piece of paper, even though it would be a simple matter to put that small amount of dmt back into solution. Long ago, I had a couple filtration processes like this go sideways on me in the past, so I'm a bit scared of filtration. (trying to remember what those projects were...sadly, I can't)
Thanks,
Slotherson

 I might find it worthwhile to combine the fridge/freezer with the saturated solvent crash for a nice dense cake of material.
I might find it worthwhile to combine the fridge/freezer with the saturated solvent crash for a nice dense cake of material.